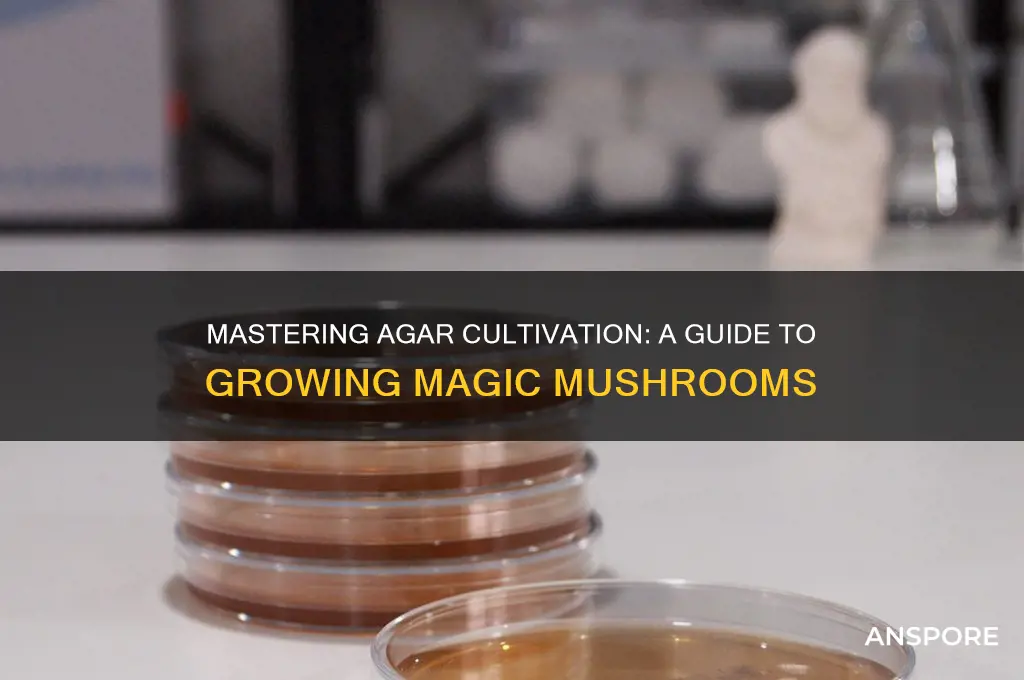
how grow agar magic mushroom

Growing agar magic mushrooms involves a precise and sterile process that begins with preparing a nutrient-rich agar medium, typically using ingredients like malt extract, yeast, and agar. This medium is sterilized to eliminate contaminants, then inoculated with mushroom mycelium, often from a spore syringe or tissue culture. The agar plates are incubated in a controlled environment to encourage mycelial growth, which can later be transferred to bulk substrates like grain or manure to fruit mushrooms. Maintaining strict sterility throughout the process is crucial to prevent contamination and ensure successful cultivation. This method is favored for its reliability and ability to produce healthy, robust mycelium.
Explore related products
$14.99
What You'll Learn
- Substrate Preparation: Sterilize straw, manure, or grain mix for optimal mycelium growth
- Agar Inoculation: Use sterile techniques to transfer mycelium to agar plates
- Incubation Conditions: Maintain 70-75°F and darkness for agar colonization
- Grain Spawn Creation: Transfer colonized agar to grain jars for bulk growth
- Fruiting Chamber Setup: Control humidity, light, and airflow for mushroom pinning

Substrate Preparation: Sterilize straw, manure, or grain mix for optimal mycelium growth
Substrate preparation is a critical step in cultivating magic mushrooms, as it directly influences the success of mycelium colonization. To ensure optimal growth, the substrate—whether straw, manure, or grain mix—must be properly sterilized to eliminate competing microorganisms. Begin by selecting high-quality organic materials, as pesticides or chemicals can hinder mycelium development. Straw should be fresh and free from mold, while manure must be well-aged to avoid ammonia toxicity. Grain mixes, such as rye or wheat, should be clean and free from debris. Proper hydration is also essential; soak straw in water for 24 hours or until it absorbs moisture evenly, while grains should be rinsed and drained before use.
Sterilization is the cornerstone of substrate preparation, as it creates a sterile environment for mycelium to thrive. The most common method is pressure cooking, which involves placing the substrate in a sterilized container and processing it in a pressure cooker at 15 PSI for 1.5 to 2 hours. For straw, loosely pack it into mesh bags or perforated containers to allow steam penetration. Manure should be mixed with water to create a paste-like consistency before sterilization. Grain mixes require precise moisture levels—aim for a 60:40 ratio of grain to water by volume. Always ensure the pressure cooker’s gasket is in good condition to maintain a proper seal, preventing contamination.
After sterilization, allow the substrate to cool to room temperature in a clean, sterile environment. This step is crucial, as introducing the substrate to agar or spawn while it’s still hot can kill the mycelium. Place the sterilized substrate in a still-air box or a clean area covered with a cloth to prevent airborne contaminants. For straw and manure, break up any clumps gently to ensure even colonization. Grain mixes should be shaken or stirred to distribute moisture and prevent compaction. Proper cooling and handling minimize the risk of contamination during the inoculation process.
For those using manure or straw, supplementation with nutrients can enhance mycelium growth. Mix in a small amount of gypsum or limestone to provide calcium and improve substrate structure. Avoid over-supplementing, as this can unbalance the nutrient profile and attract contaminants. Grain mixes typically require no additional amendments, as they provide sufficient nutrients on their own. Once prepared, the substrate should be used immediately or stored in a sealed, sterile container until inoculation to maintain its sterile state.
Consistency and attention to detail during substrate preparation are key to successful magic mushroom cultivation. Always work in a clean environment, using sterilized tools and wearing gloves to minimize contamination risks. Label containers with the sterilization date and substrate type for organization. By mastering the sterilization of straw, manure, or grain mix, growers create an ideal foundation for robust mycelium growth, setting the stage for a bountiful harvest.
Are Magic Mushroom Grow Kits Legal in South Africa?
You may want to see also

Agar Inoculation: Use sterile techniques to transfer mycelium to agar plates
Agar inoculation is a critical step in cultivating magic mushrooms, as it involves transferring mycelium to a sterile agar plate to promote healthy growth. To begin, ensure your workspace is clean and sterile to minimize contamination. Use a laminar flow hood or a still-air box if available, as these tools help maintain a sterile environment by filtering out airborne particles. Sterilize all equipment, including scalpels, inoculation loops, and tweezers, using alcohol or a flame to kill any potential contaminants. Prepare your agar plates in advance, allowing them to cool and solidify in a sterile environment before use. The agar serves as a nutrient-rich medium for the mycelium to grow, making it an ideal substrate for this stage.
Once your workspace and tools are sterile, carefully open the container holding your mycelium culture or spore syringe. If using a spore syringe, shake it gently to distribute the spores evenly. For mycelium cultures, ensure the sample is healthy and free of contaminants. Using a sterilized inoculation loop or scalpel, carefully collect a small piece of mycelium or a drop of spore solution. The goal is to transfer the smallest amount necessary to avoid introducing impurities. Hold the agar plate lid slightly ajar to minimize exposure to the air, and swiftly but gently streak the mycelium or spores onto the agar surface in a zigzag pattern. This technique helps distribute the mycelium evenly while reducing the risk of contamination.
After inoculation, quickly close the agar plate to maintain sterility. Label the plate with the date and type of culture for future reference. Place the inoculated plate in a warm, dark environment, ideally at a temperature between 70-75°F (21-24°C), to encourage mycelial growth. Avoid disturbing the plate during this period, as movement can introduce contaminants or disrupt the growth process. Regularly inspect the plate for signs of contamination, such as unusual colors or molds, which may indicate the presence of unwanted organisms. If contamination is detected, discard the plate immediately to prevent it from spreading to other cultures.
Sterile technique is paramount throughout the agar inoculation process. Always work with clean hands and wear gloves if possible. Ensure all materials and tools are sterilized before use, and minimize exposure of the agar plate to open air. Practice patience and precision, as rushing or being careless can lead to contamination, which can ruin weeks of effort. With proper care, the mycelium should begin colonizing the agar within a few days to a week, forming a white, web-like growth that indicates successful inoculation.
Once the mycelium has fully colonized the agar plate, it can be used to inoculate bulk substrates like grain or manure, advancing the cultivation process. Agar inoculation serves as a reliable method for expanding mycelium cultures and ensuring their purity, making it an essential skill for anyone growing magic mushrooms. By maintaining strict sterile techniques and attention to detail, you can create a healthy foundation for a successful mushroom cultivation project.
Exploring Africa's Fungal Diversity: Do Mushrooms Thrive in African Ecosystems?
You may want to see also

Incubation Conditions: Maintain 70-75°F and darkness for agar colonization
Creating the ideal incubation conditions is crucial for successful agar colonization when growing magic mushrooms. The primary goal is to maintain a temperature range of 70-75°F (21-24°C), as this range mimics the natural environment in which mycelium thrives. Fluctuations outside this range can slow down colonization or even halt growth entirely. Use a reliable thermometer or a temperature-controlled environment, such as an incubator or a well-insulated grow space, to monitor and regulate the temperature consistently. If natural room temperature is unstable, consider using heating pads, thermostats, or fans to maintain the desired range.
Darkness is equally important during the incubation phase. Mycelium does not require light to grow and, in fact, exposure to light can hinder colonization or lead to contamination. Store your agar plates or jars in a dark location, such as a closed cabinet, closet, or dedicated grow tent. If complete darkness is not feasible, cover the containers with opaque material like aluminum foil or black construction paper to block out light. Ensure the area remains undisturbed to avoid accidental light exposure during checks or maintenance.
Humidity is another factor to consider, though it is less critical during the agar colonization stage compared to later phases of mushroom cultivation. However, maintaining a moderately humid environment (around 50-70% relative humidity) can help prevent the agar from drying out, which could stress the mycelium. If the air is too dry, place a tray of water near the incubation area or use a small humidifier to add moisture. Avoid excessive humidity, as it can promote contamination from mold or bacteria.
Airflow should be minimal during incubation to prevent contaminants from entering the agar plates or jars. Avoid placing the containers in areas with drafts or frequent air movement. If using a grow tent or incubator, ensure it has a proper seal to keep out dust and spores from the environment. Periodically inspect the incubation area for signs of contamination, such as unusual colors, smells, or textures on the agar, and remove any affected plates or jars immediately to protect the rest of the culture.
Patience is key during the incubation period, as agar colonization can take anywhere from 7 to 14 days, depending on the mushroom strain and environmental conditions. Resist the urge to frequently open or disturb the containers, as this increases the risk of contamination and can disrupt the mycelium's growth. Instead, observe progress through the container's lid or wrapping, and only handle the agar when necessary, such as transferring mycelium to a new substrate. By maintaining the correct temperature, darkness, humidity, and minimal airflow, you create an optimal environment for healthy and efficient agar colonization.
Where to Find Morel Mushrooms in Tennessee: A Forager's Guide
You may want to see also
Explore related products

Grain Spawn Creation: Transfer colonized agar to grain jars for bulk growth
Once your agar has been successfully colonized by the mycelium, the next critical step in growing magic mushrooms is transferring this mycelium to grain jars. This process, known as grain spawn creation, allows the mycelium to expand and multiply in a nutrient-rich substrate, preparing it for bulk growth in a larger container or fruiting chamber. Begin by preparing your grain jars, which typically contain a mixture of hydrated and sterilized grains such as rye, wheat, or millet. Ensure the jars are properly sterilized to prevent contamination, as any competing microorganisms can hinder mycelial growth.
To initiate the transfer, allow the grain jars to cool to room temperature after sterilization. Using a sterile technique, open the jar in front of a still air box or laminar flow hood to minimize the risk of contamination. Take a scalpel or inoculation loop, flame-sterilize it, and carefully cut a small piece of colonized agar from the petri dish. Introduce this agar slice into the grain jar, placing it just below the surface of the grains. Seal the jar with a lid or cover it with foil secured by an elastic band to maintain a sterile environment.
After inoculation, place the grain jars in a warm, dark environment with temperatures between 75°F and 80°F (24°C to 27°C). This temperature range promotes rapid mycelial growth. Monitor the jars daily for signs of colonization, which typically begins within 5 to 7 days. The mycelium will spread through the grains, turning them white as it consumes the substrate. Full colonization usually takes 10 to 14 days, depending on the mushroom species and environmental conditions.
Once the grains are fully colonized, they are ready to be used as spawn for bulk growth. At this stage, the grain spawn can be transferred to a larger substrate, such as pasteurized straw or manure, in a bulk grow container. This step significantly increases the mycelial mass, setting the stage for fruiting. Properly prepared grain spawn is the backbone of a successful magic mushroom cultivation process, ensuring robust and healthy mushroom yields.
Throughout the grain spawn creation process, maintain strict sterile practices to avoid contamination. Contaminated jars should be discarded immediately to prevent the spread of mold or bacteria. With patience and attention to detail, transferring colonized agar to grain jars will provide a strong foundation for the next phases of mushroom cultivation, ultimately leading to a bountiful harvest.
Grow Mushrooms at Home: Simple Steps from Store-Bought Varieties
You may want to see also

Fruiting Chamber Setup: Control humidity, light, and airflow for mushroom pinning
To successfully grow magic mushrooms from agar, setting up an optimal fruiting chamber is crucial for inducing pinning and healthy mushroom development. The fruiting chamber must precisely control humidity, light, and airflow to mimic the mushrooms' natural environment. Start by selecting a container such as a clear plastic tub or a grow tent, ensuring it’s large enough to accommodate your substrate and allow for proper air circulation. Line the bottom with a tray of water or use a humidifier to maintain humidity levels between 90-95%, as this range encourages pinning. Cover the water tray with perforated foil or mesh to create a stable humid surface without saturating the substrate.
Lighting in the fruiting chamber should be indirect and consistent, as magic mushrooms do not require intense light but need a day-night cycle to trigger fruiting. Use a timer to provide 12 hours of low-intensity light (such as LED or fluorescent bulbs) and 12 hours of darkness daily. Avoid direct sunlight, as it can overheat the chamber and dry out the substrate. The light should be positioned above the mushrooms but not too close to prevent overheating or drying.
Airflow is another critical factor in preventing contamination and ensuring healthy mushroom growth. Stagnant air can lead to mold or bacteria growth, while excessive airflow can dehydrate the substrate. Install a small fan or use passive airflow by slightly opening the chamber lid or drilling small vents. The goal is to create a gentle exchange of air without causing rapid humidity loss. Monitor the chamber regularly to ensure the airflow is adequate but not disruptive.
Temperature control is also essential, as magic mushrooms fruit best between 70-75°F (21-24°C). Use a thermostat-controlled heating mat or space heater if your environment is cooler, and avoid placing the chamber near drafts or heat sources. Fluctuations in temperature can stress the mycelium and hinder pinning. Maintain a stable environment by monitoring conditions daily and adjusting as needed.
Finally, mist the inside of the fruiting chamber and the mushrooms lightly once or twice a day to maintain humidity without oversaturating the substrate. Use filtered or distilled water to avoid introducing contaminants. Once pins begin to form, reduce direct misting to prevent water from pooling on the mushrooms, which can cause rot. With consistent monitoring and adjustments, your fruiting chamber will provide the ideal conditions for magic mushrooms to thrive and produce a successful harvest.
Are Yard Mushrooms Safe? Identifying Risks in Your Backyard Fungi
You may want to see also
Frequently asked questions
Potato dextrose agar (PDA) and malt extract agar (MEA) are commonly used for growing magic mushrooms due to their nutrient content and compatibility with mycelium growth.
Sterilize agar by placing it in a pressure cooker at 15 PSI for 30–45 minutes to kill any contaminants and ensure a clean environment for mycelium growth.
No, agar plates should not be reused as they can become contaminated or depleted of nutrients, compromising the success of future grow cycles.
Mycelium typically colonizes agar within 7–14 days, depending on the mushroom strain, temperature, and environmental conditions.
Discard contaminated agar plates immediately to prevent the spread of contaminants and sterilize your workspace thoroughly before starting a new batch.

























